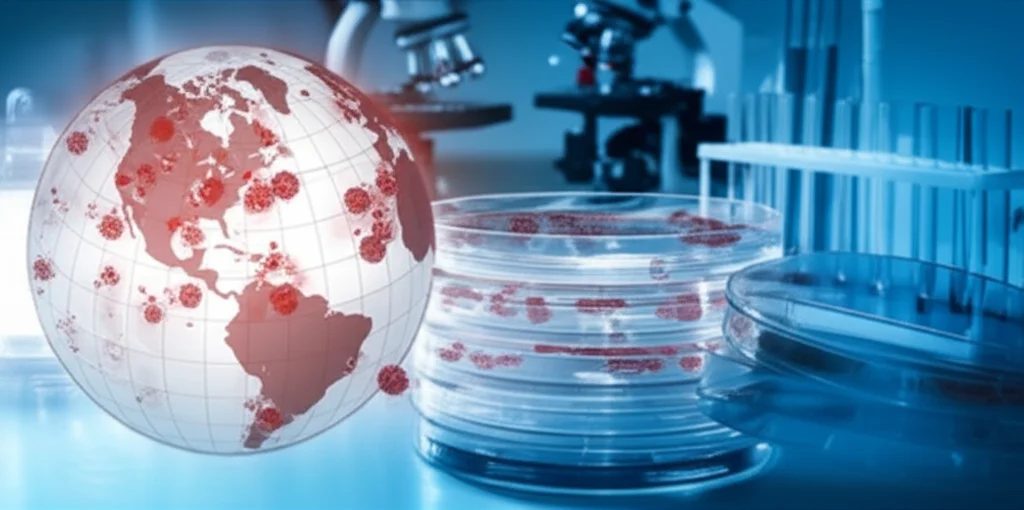
Mappamondo stilizzato che mostra la diffusione globale di un ceppo batterico resistente, con aree evidenziate in rosso. In primo piano, dettagli di laboratorio come piastre Petri e microscopi. Wide-angle, 24mm, focus nitido, atmosfera di urgenza scientifica.

Acinetobacter Baumannii: Cronaca di un Superbatterio Sempre Più Furbo e Resistente!
Amici scienziati (e non!), oggi voglio portarvi nel mondo un po’ inquietante ma incredibilmente affascinante dei batteri resistenti agli antibiotici. E non parliamo di un batterio qualsiasi, ma di un vero osso duro: l’Acinetobacter baumannii, in particolare una sua “famiglia” nota come GC1, lineage 1. Pensate, questa stirpe è emersa negli anni ’70 e da allora non ha fatto altro che diventare sempre più tosta, accumulando resistenze come se fossero figurine Panini.
Un Nemico Silenzioso e Sempre Più Forte
L’Acinetobacter baumannii è un cliente abituale negli ospedali, causando infezioni difficili da trattare, specialmente in pazienti vulnerabili. Il problema è che questo microrganismo è un maestro nell’arte dell’evoluzione, soprattutto quando si tratta di schivare i nostri antibiotici. Immaginatevelo come un videogioco in cui il boss finale diventa più forte ogni volta che lo sconfiggete parzialmente. Ecco, l’A. baumannii è un po’ così.
La sua capacità di causare epidemie, soprattutto in contesti di crisi come disastri naturali o guerre, lo rende un sorvegliato speciale. Capire come fa a insediarsi e a diffondersi tra i pazienti è cruciale se vogliamo sperare di interrompere la sua avanzata. Tra le varie “famiglie” di A. baumannii, due sono le più diffuse globalmente: GC1 e GC2. Anche se GC2 sembra essere più numerosa in termini di genomi sequenziati, non dobbiamo sottovalutare GC1, perché è un vero campione di trasformismo e resistenza.
Le Radici del “Superbatterio”: La Lineage 1 di GC1
La lineage 1 di GC1, quella di cui parliamo oggi, è nata più o meno a metà degli anni ’70. Il suo “atto di nascita” è stato l’acquisizione di un complesso pacchetto di geni di resistenza chiamato AbaR0, che ne conteneva ben sette! Questo pacchetto si è inserito nel cromosoma del batterio, in un gene chiamato comM, e da lì è iniziata la sua scalata verso la “super-resistenza”.
Questa lineage 1 ha avuto un successo strepitoso, diffondendosi in tutti i continenti abitati. E non si è accontentata: ha continuato a evolvere, acquisendo resistenze a nuovi antibiotici man mano che venivano introdotti e modificando anche la sua “carrozzeria” esterna, ovvero i polisaccaridi di superficie. Questi cambiamenti sono codificati in regioni del cromosoma note come KL (per la capsula) e OCL (per il lipooligosaccaride). Insomma, un vero camaleonte genetico!
Sotto i Riflettori: La Sottolinea MRSN56
Recentemente, l’attenzione si è concentrata su una particolare sottolinea di questa lineage 1, chiamata MRSN56. Questa “gang” batterica è stata identificata in seguito a un’epidemia in tre strutture sanitarie militari collegate ai conflitti in Iraq e Afghanistan, tra il 2007 e il 2010. Gli isolati di questa sottolinea erano incredibilmente simili tra loro, quasi dei cloni, e condividevano un arsenale di geni di resistenza impressionante.
Prendiamo ad esempio l’isolato MRSN56, il cui genoma è stato completamente sequenziato. Portava con sé geni che lo rendevano resistente a kanamicina, neomicina, gentamicina, streptomicina, spectinomicina e sulfonamidi, grazie a una versione modificata di AbaR0 chiamata AbaR28. Ma non finisce qui! Aveva anche il gene oxa23, che conferisce resistenza ai carbapenemi (antibiotici potentissimi), localizzato in un altro “pacchetto genetico mobile” chiamato AbaR4. Curiosamente, mentre AbaR28 si era piazzato nel sito preferenziale comM, AbaR4 si era trovato una posizione tutta sua, unica.
E ancora: due copie di un altro elemento genetico, Tn7, che portava geni per la resistenza a trimetoprim, streptomicina e spectinomicina. Una di queste copie, parte di una struttura più grande chiamata Tn7+, includeva anche geni per la resistenza alla tetraciclina e al sulfametoxazolo. Per non parlare della resistenza ai fluorochinoloni, ottenuta con una furbata: una mutazione nel gene gyrA combinata con l’inattivazione di un gene regolatore, marR, grazie all’inserimento di una sequenza mobile chiamata ISAba1. Quest’ultima era presente in ben 17 copie sparse nel cromosoma di MRSN56! Un vero arsenale.

Alcuni isolati di questa sottolinea portavano anche il gene aphA6 per la resistenza all’amikacina, un altro antibiotico importante. Insomma, questi batteri erano (e sono) equipaggiati di tutto punto per resistere a un gran numero di terapie.
L’Evoluzione Non Si Ferma: Il “Cambio di Costume” KL17 e Nuove Armi Genetiche
Ma la storia si fa ancora più interessante. Nel 2018, in Afghanistan, sono stati isolati due ceppi, MRSN571146 e MRSN576822, da civili. Questi due “nuovi arrivati”, pur essendo imparentati con il gruppo MRSN56, mostravano delle differenze significative. La più evidente? Avevano cambiato “costume”: al posto della capsula di tipo KL1, tipica del gruppo MRSN56, sfoggiavano una capsula KL17. Questo “cambio d’abito” avviene tramite ricombinazione genetica, sostituendo un intero set di geni nel locus K.
Ma non era solo una questione di apparenza. Questi ceppi KL17 avevano acquisito due ulteriori geni di resistenza: blaNDM-1 e strA. Il primo, blaNDM-1, è particolarmente preoccupante perché conferisce resistenza a quasi tutti gli antibiotici beta-lattamici, inclusi i carbapenemi, e può ridurre l’efficacia persino di nuovi farmaci come il cefiderocol. Il secondo, strA, aggiunge ulteriore resistenza alla streptomicina.
Analizzando a fondo i genomi di MRSN571146 e MRSN576822, abbiamo scoperto dove si nascondevano questi nuovi geni. Erano parte di un grosso segmento di DNA (circa 61 kb) inserito in un gene tRNA-glicina, tra il locus KL17 e un altro gene chiamato parC. Questo segmento, che abbiamo chiamato Aci-IE1 (Acinetobacter integrative element 1), è una sorta di “isola genomica” che include un trasposone (Tn7818) contenente blaNDM-1, strAB e una seconda copia di sul2 (resistenza ai sulfonamidi). Pensate, questo Aci-IE1 è stato trovato anche in alcuni isolati di GC2 in India, suggerendo che questo “pacchetto di resistenza” può saltare tra diverse linee di A. baumannii.
La cosa notevole è che i ceppi KL17 sembrano aver soppiantato la forma originale KL1. Infatti, analizzando genomi disponibili pubblicamente, abbiamo trovato che gli isolati KL17 sono stati raccolti tra il 2014 e il 2021, quindi più recentemente rispetto agli isolati KL1 del gruppo MRSN56 (2007-2010). E non solo: questi ceppi KL17 sono stati trovati in diversi paesi, indicando una diffusione ben più ampia.
Ancora Più Potente: L’Arrivo di *blaPER* e Altri “Potenziamenti”
L’evoluzione di questa sottolinea non si è fermata con KL17 e Aci-IE1. Alcuni isolati KL17, come un ceppo chiamato AR_0083 (la cui origine esatta non è nota ma è conservato dalla CDC AR Isolate Bank), hanno fatto un ulteriore “upgrade”. AR_0083, anch’esso di tipo ST1:KL17:OCL1, condivide molte delle caratteristiche di resistenza di MRSN56 e dei ceppi KL17 più recenti, inclusa la presenza di Aci-IE1. Ma ha qualcosa in più.
In questo ceppo, l’elemento Tn7+ (quello che portava resistenza a tetraciclina e sulfametoxazolo) è stato ulteriormente “gonfiato” da un segmento aggiuntivo di 34.6 kb, creando una super-isola di resistenza chiamata Tn7++. Questo nuovo pezzo include un altro pacchetto di geni (PTn7819) che porta armA (resistenza a tutti gli aminoglicosidi terapeuticamente rilevanti, inclusa la tobramicina a cui AR_0083 è resistente), msrE-mphE (resistenza ai macrolidi), cmlA5 (resistenza al cloramfenicolo), arr (resistenza alla rifampicina) e, udite udite, blaPER-1. Quest’ultimo, come blaNDM, contribuisce a ridurre la sensibilità al cefiderocol. Insomma, un vero incubo terapeutico!

È interessante notare come questo “modulo” Tn7++ non sia presente in tutti i ceppi KL17 più recenti. L’albero filogenetico suggerisce che il segmento aggiuntivo potrebbe essere stato acquisito presto nell’evoluzione del gruppo KL17 e poi perso in alcuni sottogruppi, probabilmente tramite ricombinazione. Questa dinamica di acquisizione e perdita di geni di resistenza è tipica di questi batteri super-adattabili.
Dalle Zone di Conflitto al Mondo Intero: La Diffusione Inarrestabile
Se la sottolinea MRSN56 originale (KL1) era fortemente associata ai conflitti in Iraq e Afghanistan, la sua versione “evoluta” KL17 ha chiaramente preso il largo. I primi isolati KL17 sono stati trovati in Nepal nel 2014, circa quattro anni dopo gli ultimi isolati KL1. Questo suggerisce che il “salto evolutivo” potrebbe essere avvenuto in quel lasso di tempo.
La presenza della branca KL17 in paesi come Sud Africa, Libano, Egitto, India, Pakistan, USA, oltre a quelli vicini all’Iraq e all’Afghanistan, testimonia una disseminazione molto più ampia. È come se il cambio di capsula da KL1 a KL17, insieme all’acquisizione di Aci-IE1, avesse conferito a questi batteri una maggiore capacità di diffondersi e colonizzare nuovi ambienti e ospiti. Chissà se la diversa struttura della capsula giochi un ruolo diretto in questa maggiore “fitness” diffusiva. È una domanda ancora aperta!
Come Abbiamo Scoperto Tutto Questo? Un Lavoro da Detective Genetico
Per ricostruire questa intricata storia evolutiva, ci siamo avvalsi di tecniche di genomica comparativa. Abbiamo sequenziato completamente i genomi di MRSN571146 e MRSN576822 e li abbiamo confrontati con quello di MRSN56 e con altri genomi disponibili pubblicamente. Abbiamo cercato specifiche “firme” genetiche, come i confini delle isole di resistenza (AbaR4, AbaR28, Tn7, Aci-IE1) e la presenza di particolari geni.
Un altro strumento potente è stata la mappatura delle sequenze di inserzione ISAba1. Queste piccole sequenze di DNA tendono a “saltare” nel genoma e a rimanere in posizioni stabili, agendo come dei veri e propri “segnalibri” evolutivi. Confrontando le posizioni di queste ISAba1 “solitarie” (cioè non associate direttamente a geni di resistenza) tra i vari isolati, possiamo inferire relazioni di parentela e tracciare la storia evolutiva di una sottolinea.
Ad esempio, i ceppi KL17 MRSN571146, MRSN576822 e AR_0083 condividono 12 delle 15 posizioni di ISAba1 solitarie trovate in MRSN56, più una nuova posizione comune a loro. Questo indica una chiara discendenza. Tuttavia, in alcuni isolati KL17, soprattutto quelli provenienti da Egitto, Libano e Nepal, molte di queste ISAba1 condivise sembravano mancare. Questo è un po’ un mistero: potrebbero essere state perse per qualche meccanismo sconosciuto, oppure potrebbe essere un artefatto legato a come sono stati processati i dati di sequenziamento. È un aspetto che necessita ulteriori indagini, data l’importanza di queste sequenze per tracciare la diffusione dei batteri.
Cosa Significa Tutto Questo Per Noi?
Beh, diciamocelo chiaramente: l’evoluzione di ceppi di A. baumannii così estensivamente resistenti è una pessima notizia. Ogni nuovo gene di resistenza acquisito, ogni “upgrade” nel loro arsenale, riduce le nostre opzioni terapeutiche. La comparsa di geni come blaNDM e blaPER, che compromettono l’efficacia anche di antibiotici di nuova generazione come il cefiderocol o combinazioni come sulbactam/durlobactam, è particolarmente allarmante.
Pensateci: tutti gli isolati di questa sottolinea MRSN56 (sia KL1 che KL17) portano il gene oxa23 (resistenza ai carbapenemi) e il gene aacC1 (resistenza alla gentamicina). Questo lasciava come opzioni tra gli aminoglicosidi solo amikacina e tobramicina. Ma abbiamo visto che molti ceppi hanno acquisito aphA6 (resistenza all’amikacina) o armA (resistenza a tutti gli aminoglicosidi, inclusa la tobramicina). È una continua corsa agli armamenti.
Capire i meccanismi con cui questi batteri evolvono, come acquisiscono e perdono geni di resistenza, e come si diffondono, è fondamentale per sviluppare strategie di controllo efficaci. La sorveglianza genomica, come quella che ha permesso di identificare e caratterizzare questa sottolinea, gioca un ruolo chiave. Ci permette di vedere il nemico, di capire le sue mosse e, si spera, di anticiparlo.
La Corsa Agli Armamenti Continua
La storia della sottolinea MRSN56 e della sua evoluzione nella forma KL17 è un esempio lampante di come i batteri possano adattarsi rapidamente e diventare minacce formidabili. Non sono coinvolti plasmidi importanti in questa evoluzione (a parte un piccolo plasmide Rep_3 senza geni di resistenza, ma molto comune in GC1 lineage 1), ma piuttosto l’acquisizione e la modificazione di elementi genetici direttamente nel cromosoma.
Il passaggio da KL1 a KL17 sembra aver dato una marcia in più a questa sottolinea, permettendole una diffusione più ampia. La battaglia contro l’antibiotico-resistenza è tutt’altro che vinta, e nemici come l’Acinetobacter baumannii ci ricordano costantemente che non possiamo abbassare la guardia. La ricerca deve continuare, per trovare nuovi farmaci, nuove strategie e per capire sempre meglio questi affascinanti quanto pericolosi microrganismi.
Fonte: Springer Nature
